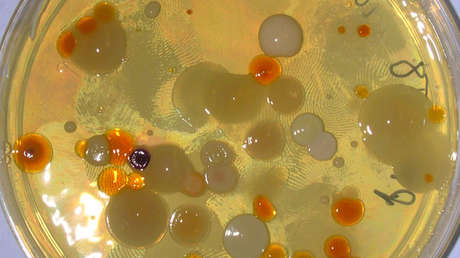
Bacterias sobreviven 1.000 días sin comer y podrían hacerlo hasta 100.000 años

Un equipo de microbiólogos de EE.UU. sometió a 100 poblaciones de bacterias extraídas del suelo y pertenecientes a 21 taxones distintos a una ausencia total de alimento durante 1.000 días. Al final de la prueba, todos los taxones participantes menos uno sobrevivieron a la hambruna, y sus tasas de mortalidad siguieron disminuyendo con el tiempo.
Los autores del experimento reportaron la semana pasada en la revista estadounidense Proceedings of the National Academy of Sciences que, genéticamente, los especímenes supervivientes continuaron evolucionando y que en ese lapso acumularon cientos de mutaciones que pueden considerarse indicios moleculares de una adaptación. Esto fue posible a pesar de que los microbios no podían reproducirse debido a la carencia de recursos externos y que el único alimento que tenían a su disposición eran restos de células muertas.
Que los microbios sobrevivieran más de dos años y medio en sistemas cerrados y experimentando un mínimo de muertes significa que podrían seguir viviendo en esas condiciones durante 100 o 105 años, aunque esa cifra podría ser incluso más alta, calculó el equipo. De hecho, un análisis estadístico situó en 100.000 años el periodo detiempo que podrían vivir los bacilos más longevos de esta muestra.
"Obviamente, estas predicciones se extienden mucho más allá de lo que se puede medir", admitió el profesor de la Universidad de Indiana Jay Lennon, "pero los números son consistentes con las edades de bacterias viables que se han recuperado de materiales antiguos, como ámbar, cristales de halita, permafrost y sedimentos del fondo de los océanos más profundos".
Así, las conclusiones del equipo corroboran la información previamente conocida de hallazgos de bacterias vivas recuperadas de distintas muestras ambientales antiguas. Además, brindan datos adicionales sobre el mecanismo de esta increíble persistencia ante la inanición completa, que son básicamente los mismos que permiten que algunos microbios que se encuentran en el cuerpo humano o animal sobrevivan a tratamientos con fármacos antimicrobianos, creen los investigadores.
Los medicamentos normalmente están diseñados para atacar el aparato celular de las células metabólicamente activas, explica Lennon en un comunicado, mientras que en condiciones desfavorables parte de las bacterias objetivo del ataque con medicamentos entran en un estado de inactividad que las hace menos sensibles a los tratamientos, por ejemplo, con antibióticos.
Si te ha gustado, ¡compártelo con tus amigos!